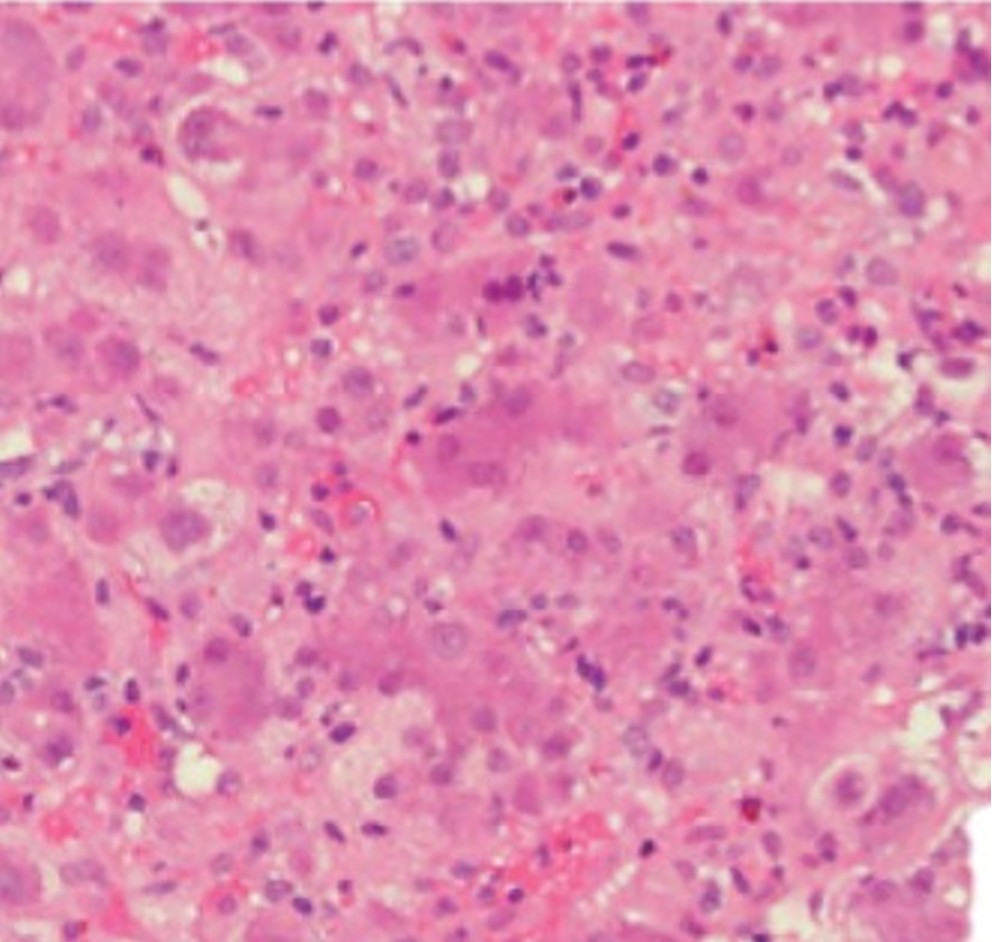

Introduction
Dear Editor,
Giant cell hepatitis with autoimmune hemolytic anemia (GCH-AHA) is a rare autoimmune disorder of infancy and early childhood with a poor prognosis. Mortality is high, often due to acute liver failure, sepsis, or complications of liver transplantation. The disease is characterized by Coombs-positive hemolytic anemia and histological evidence of multinucleated giant hepatocytes, frequently following an aggressive course despite immunosuppressive therapy.1,2 Based on the available literature and clinical records, this appears to be the second known surviving case of GCH-AHA in Turkey.
A 9-month-old male infant was diagnosed with Coombs-positive autoimmune hemolytic anemia (AHA) at 6 months of age and was receiving methylprednisolone. During steroid tapering, he developed jaundice and hepatomegaly. Laboratory evaluation revealed severe transaminase elevation (AST: 4433 U/L, ALT: 4999 U/L), hyperbilirubinemia (total: 7.43 mg/dL, direct: 4.43 mg/dL), and reticulocytosis (15.4%). Acinetobacter baumannii was produced in the blood culture, which was treated with intravenous antibiotics. Viral and autoimmune serologies were negative.
Liver biopsy demonstrated multinucleated giant hepatocytes, dense lymphoplasmacytic infiltrates, periportal/interface hepatitis, and focal eosinophils and neutrophils, consistent with GCH (Figure 1). Methylprednisolone (2 mg/kg/day) and intravenous immunoglobulin (IVIG, 1 g/kg) were started, with partial improvement by day 5. On day 10, due to clinical and biochemical deterioration, anti-CD20 monoclonal antibody (rituximab, 375 mg/m² weekly) was initiated. Azathioprine (2 mg/kg/day) was added after the third dose, and mycophenolate mofetil after the sixth dose.
The patient received a total of nine doses of rituximab and five infusions of IVIG. Complete biochemical remission was achieved within 500 days (Figure 2). At the time of writing, follow-up has reached 1000 days, with the patient remaining clinically stable on azathioprine and mycophenolate mofetil.

Previous studies have reported that rituximab may be effective in refractory GCH-AHA, although relapses are common.3, 4 Early administration, in combination with other immunosuppressants, may improve outcomes and reduce progression to liver failure. In the current case, prolonged and combined immunosuppressive therapy resulted in long-term survival with an uneventful follow-up of 1000 days. This is an exceptionally rare outcome, making this, to the best of our knowledge, the second known surviving case reported from Turkey.5 Notably, this patient received a total of nine doses of rituximab, exceeding the commonly reported regimens of four to six doses.3 This extended protocol was guided by persistent cholestatic liver enzyme elevations and incomplete remission.
Anti-CD20 monoclonal antibody therapy should be considered early in the management of steroid-refractory GCH-AHA to improve survival and prevent irreversible liver injury.
Acknowledgements
We thank Dr. Yunus Güler and Dr. Özlem Gülpınar Aydın for their contributions to this study.
Source of funding
The authors declare the study received no funding.
Conflict of interest
The authors declare that there is no conflict of interest.
References
- Csernus K, Tészás A, Ottóffy G, Dezsőfi-Gottl A, Tárnok A. Association of giant cell hepatitis and autoimmune hemolytic anemia in infancy. Orv Hetil. 2023;164:1432-6. https://doi.org/10.1556/650.2023.32848
- Maggiore G, Sciveres M, Fabre M, et al. Giant cell hepatitis with autoimmune hemolytic anemia in early childhood: long-term outcome in 16 children. J Pediatr. 2011;159:127-32.e1. https://doi.org/10.1016/j.jpeds.2010.12.050
- Bakula A, Socha P, Klaudel-Dreszler M, et al. Giant cell hepatitis with autoimmune hemolytic anemia in children: proposal for therapeutic approach. J Pediatr Gastroenterol Nutr. 2014;58:669-73. https://doi.org/10.1097/MPG.0000000000000270
- Maggiore G, Sciveres M. Giant cell hepatitis associated with autoimmune hemolytic anemia: more evidence for B-cell depletion therapy for a rare immune mediated disease of infancy. Clin Res Hepatol Gastroenterol. 2024;48:102435. https://doi.org/10.1016/j.clinre.2024.102435
- Ünal Ş, Kuşkonmaz B, Balamtekin N, et al. Autoimmune hemolytic anemia and giant cell hepatitis: report of three infants. Turk J Haematol. 2010;27:308-13. https://doi.org/10.5152/tjh.2010.55
Copyright and license
Copyright © 2025 The author(s). This is an open-access article published by Aydın Pediatric Society under the terms of the Creative Commons Attribution License (CC BY) which permits unrestricted use, distribution, and reproduction in any medium or format, provided the original work is properly cited.














